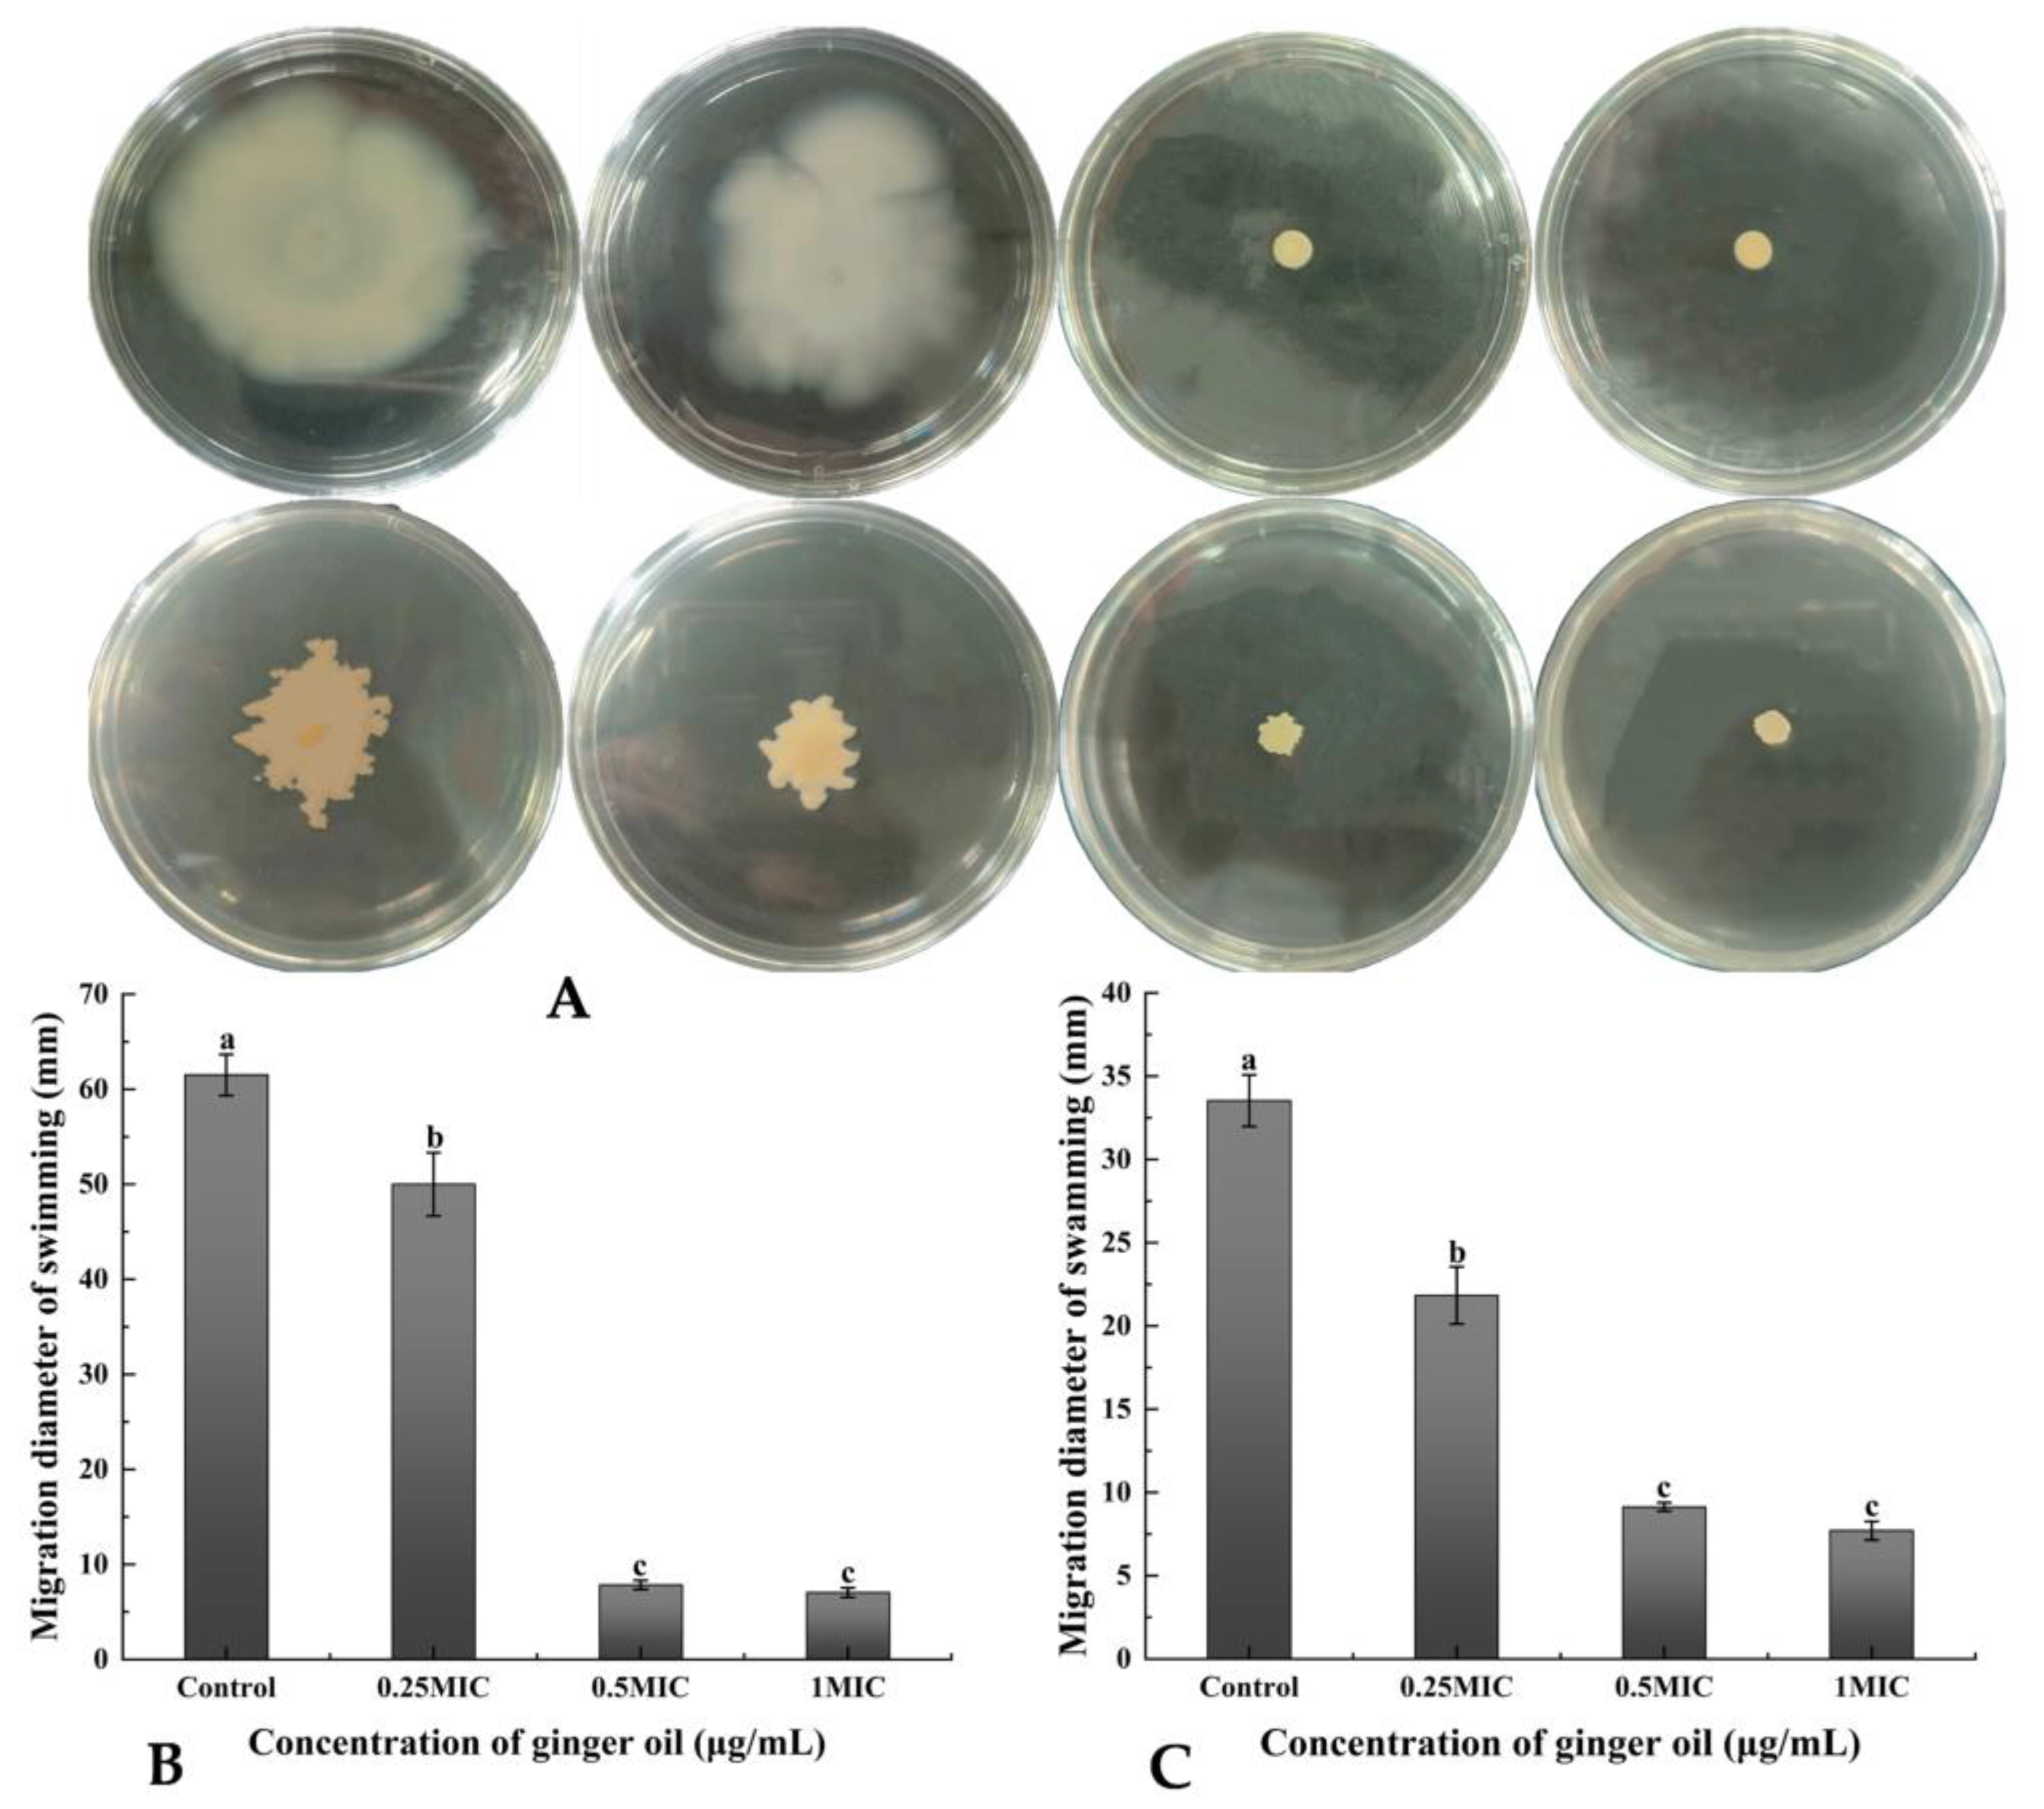

Antibacterial and Antibiofilm Efficacy and Mechanism of Ginger (Zingiber officinale) Essential Oil against Shewanella putrefaciens
Abstract
1. Introduction
2. Results
2.1. Essential Oil Composition Analysis by Gas Chromatography-Mass Spectrometry (GC-MS) Results
2.2. Results of Antibacterial Activity
2.2.1. Minimum Inhibitory Concentration (MIC) and Minimum Bactericidal Concentration (MBC)
2.2.2. Integrity of Cell Membrane
2.2.3. Intracellular ATP
2.2.4. Fourier Transform Infrared (FTIR) Spectroscopic Analysis
2.3. Results of Antibiofilm Activity
2.3.1. Growth Curve of Biofilm
2.3.2. Removal Activity
2.3.3. Inhibition of Motility by GEO
2.3.4. Inhibition of GEO on Exopolysaccharides (EPS) Production
2.3.5. Inhibition of GEO on Extracellular Protease Production
2.3.6. Biofilm Metabolic Activity
2.3.7. Scanning Electron Microscope (SEM)
2.3.8. Confocal Laser Scanning Microscopy (CLSM)
3. Discussion
4. Materials and Methods
4.1. Materials
4.2. Essential oil Composition Analysis by Gas Chromatography-Mass Spectrometry (GC-MS)
4.3. Antibacterial Activity Assay
4.3.1. MIC and MBC Determination
4.3.2. Integrity of Cell Membrane Determination
4.3.3. Intracellular ATP Determination
4.3.4. Fourier Transform Infrared Spectroscopic Analysis
4.4. Antibacterial Activity Assay
4.4.1. Biofilm Formation Determination
4.4.2. Biofilm Biomass Determination (Crystal Violet Staining Assay)
4.4.3. Growth Curve Determination of Biofilm
4.4.4. Motility Assay
4.4.5. EPS and Extracellular Protease Determination
4.4.6. Biofilm Metabolic Activity Determination (XTT Reduction Assay)
4.4.7. SEM assay
4.4.8. CLSM Assay
4.5. Statistical Analysis
5. Conclusions
Author Contributions
Funding
Institutional Review Board Statement
Informed Consent Statement
Data Availability Statement
Conflicts of Interest
References
- Pei, J.; Yu, H.; Qiu, W.; Mei, J.; Xie, J. Antimicrobial Effect of Epigallocatechin Gallate Against Shewanella putrefaciens ATCC 8071: A Study Based on Cell Membrane and Biofilm. Curr. Microbiol. 2022, 79, 297. [Google Scholar] [CrossRef] [PubMed]
- Liu, J.; Yu, S.; Han, B.; Chen, J.J.F.C. Effects of benzalkonium chloride and ethanol on dual-species biofilms of Serratia liquefaciens S1 and Shewanella putrefaciens S4. Food Control 2017, 78, 196–202. [Google Scholar] [CrossRef]
- Qian, Y.-F.; Cheng, Y.; Ye, J.-X.; Zhao, Y.; Xie, J.; Yang, S.-P. Targeting shrimp spoiler Shewanella putrefaciens: Application of ε-polylysine and oregano essential oil in Pacific white shrimp preservation. Food Control 2021, 123, 107702. [Google Scholar] [CrossRef]
- Wright, M.H.; Shalom, J.; Matthews, B.; Greene, A.C.; Cock, I.E. Terminalia ferdinandiana Exell: Extracts inhibit Shewanella spp. growth and prevent fish spoilage. Food Microbiol. 2019, 78, 114–122. [Google Scholar] [CrossRef]
- Li, A.; Shi, C.; Qian, S.; Wang, Z.; Zhao, S.; Liu, Y.; Xue, Z. Evaluation of antibiotic combination of Litsea cubeba essential oil on Vibrio parahaemolyticus inhibition mechanism and anti-biofilm ability. Microb. Pathog. 2022, 168, 105574. [Google Scholar] [CrossRef]
- Lu, J.; Hu, X.; Ren, L. Biofilm control strategies in food industry: Inhibition and utilization. Trends Food Sci. Technol. 2022, 123, 103–113. [Google Scholar] [CrossRef]
- Li, P.; Mei, J.; Xie, J. Carbon dioxide can inhibit biofilms formation and cellular properties of Shewanella putrefaciens at both 30 °C and 4 °C. Food Res. Int. 2022, 161, 111781. [Google Scholar] [CrossRef]
- Di Napoli, M.; Castagliuolo, G.; Badalamenti, N.; Maresca, V.; Basile, A.; Bruno, M.; Varcamonti, M.; Zanfardino, A. Antimicrobial, Antibiofilm, and Antioxidant Properties of Essential Oil of Foeniculum vulgare Mill. Leaves. Plants 2022, 11, 3573. [Google Scholar] [CrossRef]
- Sahal, G.; Woerdenbag, H.J.; Hinrichs, W.L.; Visser, A.; Tepper, P.G.; Quax, W.J.; van der Mei, H.C.; Bilkay, I.S. Antifungal and biofilm inhibitory effect of Cymbopogon citratus (lemongrass) essential oil on biofilm forming by Candida tropicalis isolates; an in vitro study. J. Ethnopharmacol. 2020, 246, 112188. [Google Scholar] [CrossRef]
- Yan, J.; Xie, J. Removal of Shewanella putrefaciens Biofilm by acidic electrolyzed water on food contact surfaces. LWT 2021, 151, 112044. [Google Scholar] [CrossRef]
- Tundis, R.; Xiao, J.; Silva, A.S.; Carreiró, F.; Loizzo, M.R. Health-Promoting Properties and Potential Application in the Food Industry of Citrus medica L. and Citrus × clementina Hort. Ex Tan. Essential Oils and Their Main Constituents. Plants 2023, 12, 991. [Google Scholar] [CrossRef]
- Spadaccino, G.; Frabboni, L.; Petruzzi, F.; Disciglio, G.; Mentana, A.; Nardiello, D.; Quinto, M. Essential oil characterization of Prunus spinosa L., Salvia officinalis L., Eucalyptus globulus L., Melissa officinalis L. and Mentha x piperita L. by a volatolomic approach. J. Pharm. Biomed. Anal. 2021, 202, 114167. [Google Scholar] [CrossRef]
- Yu, H.; Pei, J.; Qiu, W.; Mei, J.; Xie, J. The Antimicrobial Effect of Melissa officinalis L. Essential Oil on Vibrio parahaemolyticus: Insights Based on the Cell Membrane and External Structure. Front. Microbiol. 2022, 13, 812792. [Google Scholar] [CrossRef]
- Khan, F.A.; Khan, N.M.; Ahmad, S.; Aziz, R.; Ullah, I.; Almehmadi, M.; Allahyani, M.; Alsaiari, A.A.; Aljuaid, A.J.P. Phytochemical profiling, antioxidant, antimicrobial and cholinesterase inhibitory effects of essential oils isolated from the leaves of Artemisia scoparia and Artemisia absinthium. Pharmaceuticals 2022, 15, 1221. [Google Scholar] [CrossRef] [PubMed]
- Jan, A.K.; Hazrat, A.; Ahmad, S.; Jan, T.; Jan, G. In vitro antifungal, antibacterial, phytotoxic, brine shrimp, insecticidal activities and composition of essential oil of tagetes minuta from dir-kohistan, pakistan. Pak. J. Bot. 2019, 51, 201–204. [Google Scholar] [CrossRef] [PubMed]
- Khan, F.A.; Jan, A.K.; Khan, N.M.; Khan, N.A.; Khan, S. GC/MS analysis, antimicrobial and in vitro anti-cholinesterase activities of the essential oil from Buddleja asiatica. Bangladesh J. Pharmacol. 2015, 10, 891–895. [Google Scholar] [CrossRef]
- Alsherbiny, M.A.; Abd-Elsalam, W.H.; Taher, E.; Fares, M.; Torres, A.; Chang, D.; Li, C.G. Ameliorative and protective effects of ginger and its main constituents against natural, chemical and radiation-induced toxicities: A comprehensive review. Food Chem. Toxicol. 2019, 123, 72–97. [Google Scholar] [CrossRef]
- Kieliszek, M.; Edris, A.; Kot, A.M.; Piwowarek, K. Biological activity of some aromatic plants and their metabolites, with an emphasis on health-promoting properties. Molecules 2020, 25, 2478. [Google Scholar] [CrossRef]
- Mesomo, M.C.; Corazza, M.L.; Ndiaye, P.M.; Dalla Santa, O.R.; Cardozo, L.; de Paula Scheer, A. Supercritical CO2 extracts and essential oil of ginger (Zingiber officinale R.): Chemical composition and antibacterial activity. J. Supercrit. Fluids 2013, 80, 44–49. [Google Scholar] [CrossRef]
- Clemens, R.; Kadharmestan, C. Food. In An Overview of FDA Regulated Products; Academic Press: Cambridge, MA, USA, 2018; pp. 157–180. [Google Scholar] [CrossRef]
- Hu, J.; Zhang, Y.; Xiao, Z.; Wang, X. Preparation and properties of cinnamon-thyme-ginger composite essential oil nanocapsules. Ind. Crop. Prod. 2018, 122, 85–92. [Google Scholar] [CrossRef]
- Liu, G.; Feng, J.; Zhu, W.; Jiang, Y. Zein self-assembly using the built-in ultrasonic dialysis process: Microphase behavior and the effect of dialysate properties. Colloid Polym. Sci. 2018, 296, 173–181. [Google Scholar] [CrossRef]
- Kavas, N.; Kavas, G.; Saygili, D. Use of ginger essential oil-fortified edible coatings in Kashar cheese and its effects on Escherichia coli O157: H7 and Staphylococcus aureus. CyTA-J. Food 2016, 14, 317–323. [Google Scholar] [CrossRef]
- Guerrero, A.; Guerrero, E.; Cartuche, L.; Cumbicus, N.; Morocho, V. Chemical Profiling of Hedyosmum cumbalense and Hedyosmum spectabile (Chloranthaceae) Essential Oils, and Their Antimicrobial, Antioxidant, and Anticholinesterase Properties. Plants 2022, 12, 39. [Google Scholar] [CrossRef]
- Wang, X.-Y.; Xie, J. Response to Cold Adaption in Acinetobacter johnsonii XY27 from Spoiled Bigeye Tuna (Thunnus obesus): Membrane Protein Composition and Protein Biomarker Identification by Proteomics. J. Agric. Food Chem. 2022, 70, 10000–10010. [Google Scholar] [CrossRef] [PubMed]
- Yousfi, F.; Abrigach, F.; Petrovic, J.D.; Sokovic, M.; Ramdani, M. Phytochemical screening and evaluation of the antioxidant and antibacterial potential of Zingiber officinale extracts. S. Afr. J. Bot. 2021, 142, 433–440. [Google Scholar] [CrossRef]
- Lei, H.; Wei, Q.; Wang, Q.; Su, A.; Xue, M.; Liu, Q.; Hu, Q. Characterization of ginger essential oil/palygorskite composite (GEO-PGS) and its anti-bacteria activity. Mater. Sci. Eng. C 2017, 73, 381–387. [Google Scholar] [CrossRef]
- Thongson, C.; Davidson, P.M.; Mahakarnchanakul, W.; Vibulsresth, P. Antimicrobial effect of Thai spices against Listeria monocytogenes and Salmonella Typhimurium DT104. J. Food Prot. 2005, 68, 2054–2058. [Google Scholar] [CrossRef]
- Singh, G.; Kapoor, I.; Singh, P.; de Heluani, C.S.; de Lampasona, M.P.; Catalan, C.A. Chemistry, antioxidant and antimicrobial investigations on essential oil and oleoresins of Zingiber officinale. Food Chem. Toxicol. 2008, 46, 3295–3302. [Google Scholar] [CrossRef] [PubMed]
- Xu, D.; Sun, L.; Li, C.; Wang, Y.; Ye, R. Inhibitory effect of glucose oxidase from Bacillus sp. CAMT22370 on the quality deterioration of Pacific white shrimp during cold storage. LWT 2018, 92, 339–346. [Google Scholar] [CrossRef]
- Zhang, Y.; Wang, Y.; Zhu, X.; Cao, P.; Wei, S.; Lu, Y. Antibacterial and antibiofilm activities of eugenol from essential oil of Syzygium aromaticum (L.) Merr. & LM Perry (clove) leaf against periodontal pathogen Porphyromonas gingivalis. Microb. Pathog. 2017, 113, 396–402. [Google Scholar]
- Song, J.; Chen, H.; Wei, Y.; Liu, J. Synthesis of carboxymethylated β-glucan from naked barley bran and its antibacterial activity and mechanism against Staphylococcus aureus. Carbohydr. Polym. 2020, 242, 116418. [Google Scholar] [CrossRef]
- Liu, F.; Tang, C.; Wang, D.; Sun, Z.; Du, L.; Wang, D. The synergistic effects of phenyllactic acid and slightly acid electrolyzed water to effectively inactivate Klebsiella oxytoca planktonic and biofilm cells. Food Control 2021, 125, 107804. [Google Scholar] [CrossRef]
- Sun, J.; Huang, L.; Sun, Z.; Wang, D.; Liu, F.; Du, L.; Wang, D. Combination of ultrasound and chlorogenic acid for inactivation of planktonic and biofilm cells of Pseudomonas fluorescens. Food Res. Int. 2022, 155, 111009. [Google Scholar] [CrossRef]
- Beristain-Bauza, S.D.C.; Hernández-Carranza, P.; Cid-Pérez, T.S.; Ávila-Sosa, R.; Ruiz-López, I.I.; Ochoa-Velasco, C.E. Antimicrobial activity of ginger (Zingiber officinale) and its application in food products. Food Rev. Int. 2019, 35, 407–426. [Google Scholar] [CrossRef]
- Kos, G.; Lohninger, H.; Krska, R. Development of a method for the determination of Fusarium fungi on corn using mid-infrared spectroscopy with attenuated total reflection and chemometrics. Anal. Chem. 2003, 75, 1211–1217. [Google Scholar] [CrossRef]
- Salman, A.; Shufan, E.; Sharaha, U.; Lapidot, I.; Mordechai, S.; Huleihel, M. Distinction between mixed genus bacteria using infrared spectroscopy and multivariate analysis. Vib. Spectrosc. 2019, 100, 6–13. [Google Scholar] [CrossRef]
- Srey, S.; Jahid, I.K.; Ha, S.-D. Biofilm formation in food industries: A food safety concern. Food Control 2013, 31, 572–585. [Google Scholar] [CrossRef]
- Cui, H.; Zhang, C.; Li, C.; Lin, L. Inhibition mechanism of cardamom essential oil on methicillin-resistant Staphylococcus aureus biofilm. LWT 2020, 122, 109057. [Google Scholar] [CrossRef]
- Millezi, A.F.; Piccoli, R.H.; Oliveira, J.M.; Pereira, M.O. Anti-biofim and antibacterial effect of essential oils and their major compounds. J. Essent. Oil Bear. Plants 2016, 19, 624–631. [Google Scholar] [CrossRef]
- Brindhadevi, K.; LewisOscar, F.; Mylonakis, E.; Shanmugam, S.; Verma, T.N.; Pugazhendhi, A. Biofilm and Quorum sensing mediated pathogenicity in Pseudomonas aeruginosa. Process Biochem. 2020, 96, 49–57. [Google Scholar] [CrossRef]
- Nazareth, M.S.; Shreelakshmi, S.; Rao, P.J.; Shetty, N.P. Micro and nanoemulsions of Carissa spinarum fruit polyphenols, enhances anthocyanin stability and anti-quorum sensing activity: Comparison of degradation kinetics. Food Chem. 2021, 359, 129876. [Google Scholar] [CrossRef] [PubMed]
- Yin, L.; Zhang, Y.; Azi, F.; Zhou, J.; Liu, X.; Dai, Y.; Wang, Z.; Dong, M.; Xia, X. Inhibition of biofilm formation and quorum sensing by soy isoflavones in Pseudomonas aeruginosa. Food Control 2022, 133, 108629. [Google Scholar] [CrossRef]
- Zhang, Y.; Kong, J.; Xie, Y.; Guo, Y.; Yu, H.; Cheng, Y.; Qian, H.; Shi, R.; Yao, W. Quorum-sensing inhibition by hexanal in biofilms formed by Erwinia carotovora and Pseudomonas fluorescens. LWT 2019, 109, 145–152. [Google Scholar] [CrossRef]
- Neu, T.R.; Lawrence, J.R. Extracellular polymeric substances in microbial biofilms. In Microbial Glycobiology; Elsevier: Amsterdam, The Netherlands, 2010; pp. 733–758. [Google Scholar]
- Colagiorgi, A.; Di Ciccio, P.; Zanardi, E.; Ghidini, S.; Ianieri, A. A look inside the Listeria monocytogenes biofilms extracellular matrix. Microorganisms 2016, 4, 22. [Google Scholar] [CrossRef] [PubMed]
- Osei-Adjei, G.; Huang, X.; Zhang, Y. The extracellular proteases produced by Vibrio parahaemolyticus. World J. Microbiol. Biotechnol. 2018, 34, 68. [Google Scholar] [CrossRef] [PubMed]
- Cao, J.; Liu, H.; Wang, Y.; He, X.; Jiang, H.; Yao, J.; Xia, F.; Zhao, Y.; Chen, X. Antimicrobial and antivirulence efficacies of citral against foodborne pathogen Vibrio parahaemolyticus RIMD2210633. Food Control 2021, 120, 107507. [Google Scholar] [CrossRef]
- Pantanella, F.; Valenti, P.; Natalizi, T.; Passeri, D.; Berlutti, F. Analytical techniques to study microbial biofilm on abiotic surfaces: Pros and cons of the main techniques currently in use. Ann. Ig. 2013, 25, 31–42. [Google Scholar]
- Xie, T.; Liao, Z.; Lei, H.; Fang, X.; Wang, J.; Zhong, Q. Antibacterial activity of food-grade chitosan against Vibrio parahaemolyticus biofilms. Microb. Pathog. 2017, 110, 291–297. [Google Scholar] [CrossRef]
- Chen, F.; Miao, X.; Lin, Z.; Xiu, Y.; Shi, L.; Zhang, Q.; Liang, D.; Lin, S.; He, B. Disruption of metabolic function and redox homeostasis as antibacterial mechanism of Lindera glauca fruit essential oil against Shigella flexneri. Food Control 2021, 130, 108282. [Google Scholar] [CrossRef]
- Yadav, M.K.; Chae, S.-W.; Im, G.J.; Chung, J.-W.; Song, J.-J. Eugenol: A phyto-compound effective against methicillin-resistant and methicillin-sensitive Staphylococcus aureus clinical strain biofilms. PLoS ONE 2015, 10, e0119564. [Google Scholar] [CrossRef]
- Wijesundara, N.M.; Lee, S.F.; Cheng, Z.; Davidson, R.; Rupasinghe, H. Carvacrol exhibits rapid bactericidal activity against Streptococcus pyogenes through cell membrane damage. Sci. Rep. 2021, 11, 1487. [Google Scholar] [CrossRef] [PubMed]
- Bodor, A.M.; Jänsch, L.; Wissing, J.; Wagner-Döbler, I. The luxS mutation causes loosely-bound biofilms in Shewanella oneidensis. BMC Res. Notes 2011, 4, 180. [Google Scholar] [CrossRef]
- Ashrafudoulla, M.; Mizan, M.F.R.; Ha, A.J.-W.; Park, S.H.; Ha, S.-D. Antibacterial and antibiofilm mechanism of eugenol against antibiotic resistance Vibrio parahaemolyticus. Food Microbiol. 2020, 91, 103500. [Google Scholar] [CrossRef]
- Liu, F.; Jin, P.; Gong, H.; Sun, Z.; Du, L.; Wang, D. Antibacterial and antibiofilm activities of thyme oil against foodborne multiple antibiotics-resistant Enterococcus faecalis. Poult. Sci. 2020, 99, 5127–5136. [Google Scholar] [CrossRef] [PubMed]
- Kumari, P.; Mishra, R.; Arora, N.; Chatrath, A.; Gangwar, R.; Roy, P.; Prasad, R. Antifungal and anti-biofilm activity of essential oil active components against Cryptococcus neoformans and Cryptococcus laurentii. Front. Microbiol. 2017, 8, 2161. [Google Scholar] [CrossRef]
- Siddique, M.H.; Hayat, S.; Muzammil, S.; Ashraf, A.; Khan, A.M.; Ijaz, M.U.; Khurshid, M.; Afzal, M. Ecofriendly phytosynthesized zirconium oxide nanoparticles as antibiofilm and quorum quenching agents against Acinetobacter baumannii. Drug Dev. Ind. Pharm. 2022, 48, 502–509. [Google Scholar] [CrossRef]
- Dai, J.; Li, C.; Cui, H.; Lin, L. Unraveling the anti-bacterial mechanism of Litsea cubeba essential oil against E. coli O157: H7 and its application in vegetable juices. Int. J. Food Microbiol. 2021, 338, 108989. [Google Scholar] [CrossRef]
- M7-A7; Wikler, M.A. Methods for Dilution Antimicrobial Susceptibility Tests for Bacteria that Grow Aerobically: Approved Standard. CLSI: Wayne, PA, USA, 2006; Volumne 26.
- Diao, W.-R.; Hu, Q.-P.; Zhang, H.; Xu, J.-G. Chemical composition, antibacterial activity and mechanism of action of essential oil from seeds of fennel (Foeniculum vulgare Mill.). Food Control 2014, 35, 109–116. [Google Scholar] [CrossRef]
- Liu, W.; Mei, J.; Xie, J. Elucidating antibacterial activity and mechanism of daphnetin against Pseudomonas fluorescens and Shewanella putrefaciens. J. Food Qual. 2020, 2020, 6622355. [Google Scholar] [CrossRef]
- Wang, N.; Liu, X.; Li, J.; Zhang, Q.; Li, X.; An, Q.; Ye, X.; Zhao, Z.; Cai, L.; Han, Y. Antibacterial mechanism of the synergistic combination between streptomycin and alcohol extracts from the Chimonanthus salicifolius SY Hu. leaves. J. Ethnopharmacol. 2020, 250, 112467. [Google Scholar] [CrossRef]
- Li, H.; Gao, Y.; Li, C.; Ma, G.; Shang, Y.; Sun, Y. A comparative study of the antibacterial mechanisms of silver ion and silver nanoparticles by Fourier transform infrared spectroscopy. Vib. Spectrosc. 2016, 85, 112–121. [Google Scholar] [CrossRef]
- Zhang, J.; Ye, K.-P.; Zhang, X.; Pan, D.-D.; Sun, Y.-Y.; Cao, J.-X. Antibacterial activity and mechanism of action of black pepper essential oil on meat-borne Escherichia coli. Front. Microbiol. 2017, 7, 2094. [Google Scholar] [CrossRef] [PubMed]
- Bian, C.; Yu, H.; Yang, K.; Mei, J.; Xie, J. Effects of single-, dual-, and multi-frequency ultrasound-assisted freezing on the muscle quality and myofibrillar protein structure in large yellow croaker (Larimichthys crocea). Food Chem. X 2022, 15, 100362. [Google Scholar] [CrossRef] [PubMed]
- Sivaranjani, M.; Gowrishankar, S.; Kamaladevi, A.; Pandian, S.K.; Balamurugan, K.; Ravi, A.V. Morin inhibits biofilm production and reduces the virulence of Listeria monocytogenes—An in vitro and in vivo approach. Int. J. Food Microbiol. 2016, 237, 73–82. [Google Scholar] [CrossRef] [PubMed]
- Mei, J.; Ma, X.; Xie, J. Review on natural preservatives for extending fish shelf life. Foods 2019, 8, 490. [Google Scholar] [CrossRef]
- Behbahani, B.A.; Noshad, M.; Falah, F. Cumin essential oil: Phytochemical analysis, antimicrobial activity and investigation of its mechanism of action through scanning electron microscopy. Microb. Pathog. 2019, 136, 103716. [Google Scholar] [CrossRef]
- Ma, X.; Mei, J.; Xie, J. Effects of multi-frequency ultrasound on the freezing rates, quality properties and structural characteristics of cultured large yellow croaker (Larimichthys crocea). Ultrason. Sonochemistry 2021, 76, 105657. [Google Scholar] [CrossRef]
- Yan, J.; Xie, J. Comparative proteome analysis of Shewanella putrefaciens WS13 mature biofilm under cold stress. Front. Microbiol. 2020, 11, 1225. [Google Scholar] [CrossRef]
- Zhang, H.; Wang, Q.; Dong, Y.; Mei, J.; Xie, J. Effects of tricaine methanesulphonate (MS-222) on physiological stress and fresh quality of sea bass (Lateolabrax maculatus) under simulated high-density and long-distance transport stress. Biology 2023, 12, 223. [Google Scholar] [CrossRef]

| No. | Retention Index | Compounds | Formula | Percentage (%) |
|---|---|---|---|---|
| 1 | 971 | Zingiberene | C15H24 | 34.4 |
| 2 | 916 | α-Curcumene | C15H22 | 13.7 |
| 3 | 974 | Zingerone | C11H14O3 | 10 |
| 4 | 899 | Santalol | C15H24O | 4.2 |
| 5 | 887 | 1,6,10-Dodecatriene,7,11-dimethyl-3-Methylene-, (6E)- | C15H24 | 4.1 |
| 6 | 1136 | Geraniol | C10H18O | 1.4 |
| 7 | 788 | Dipentene | C10H16 | 1.4 |
| 8 | 803 | Benzaldehyde | C7H6O | 0.91 |
| 9 | 572 | (+)-borneol | C10H18O | 0.65 |
| 10 | 805 | Linalool | C10H18O | 0.53 |
| 11 | 889 | Trans-Cinnamaldehyde | C9H8O | 0.52 |
| 12 | 828 | Beta-Phellandrene | C10H16 | 0.44 |
| 13 | 895 | Caryophyllene | C15H24 | 0.41 |
| 14 | 904 | Cinnamaldehyde | C9H8O | 0.41 |
| 15 | 906 | (−)-isolongifolene | C15H24 | 0.39 |
| 16 | 903 | (E, Z)-2,6-dimethylocta-2,4,6-triene | C10H16 | 0.37 |
Disclaimer/Publisher’s Note: The statements, opinions and data contained in all publications are solely those of the individual author(s) and contributor(s) and not of MDPI and/or the editor(s). MDPI and/or the editor(s) disclaim responsibility for any injury to people or property resulting from any ideas, methods, instructions or products referred to in the content. |
© 2023 by the authors. Licensee MDPI, Basel, Switzerland. This article is an open access article distributed under the terms and conditions of the Creative Commons Attribution (CC BY) license (https://creativecommons.org/licenses/by/4.0/).
Share and Cite
Zhang, C.; Xie, Y.; Qiu, W.; Mei, J.; Xie, J. Antibacterial and Antibiofilm Efficacy and Mechanism of Ginger (Zingiber officinale) Essential Oil against Shewanella putrefaciens. Plants 2023, 12, 1720. https://doi.org/10.3390/plants12081720
Zhang C, Xie Y, Qiu W, Mei J, Xie J. Antibacterial and Antibiofilm Efficacy and Mechanism of Ginger (Zingiber officinale) Essential Oil against Shewanella putrefaciens. Plants. 2023; 12(8):1720. https://doi.org/10.3390/plants12081720
Chicago/Turabian StyleZhang, Chi, Yao Xie, Weiqiang Qiu, Jun Mei, and Jing Xie. 2023. "Antibacterial and Antibiofilm Efficacy and Mechanism of Ginger (Zingiber officinale) Essential Oil against Shewanella putrefaciens" Plants 12, no. 8: 1720. https://doi.org/10.3390/plants12081720
APA StyleZhang, C., Xie, Y., Qiu, W., Mei, J., & Xie, J. (2023). Antibacterial and Antibiofilm Efficacy and Mechanism of Ginger (Zingiber officinale) Essential Oil against Shewanella putrefaciens. Plants, 12(8), 1720. https://doi.org/10.3390/plants12081720

